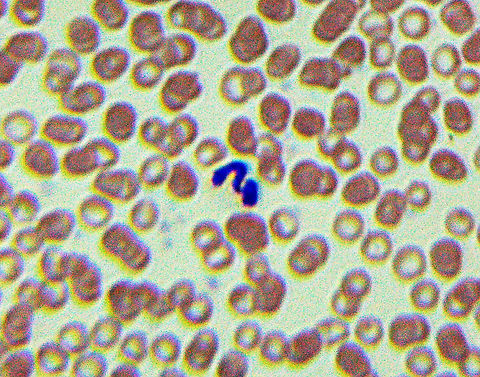
Dog Heartworm - Dirofilaria immitis The blue squiggle on this slide is Dirofilaria immitis, which causes dog heartworm. It infects the lung arteries and heart of its host, eventually leading to death. The definitive host is the dog, but it can also infect other animals such as cats, foxes, and bears. It is transmitted by mosquitoes in the genera Aedes, Culex, Anopheles, and Mansonia.

There are numerous drugs available to prevent infection.

*Slide is a blood smear  Dirofilaria,Dirofilaria immitis,Geotagged,Onchocercidae,United States,Winter,arthropod-borne disease,dirofilariasis,dog heartworm,filarial worm,heartworm,parasitic roundworm,roundworm

Tiny Horrors
This list includes the small, horrifying creatures that are parasitic on animals. Parasites are organisms that live on or in a host -- to the host's detriment.
Christine Young created this list 4 years ago
-

Flea Tapeworm Eggs - Dipylidium caninum -

Shigella dysenteriae -

Chinese Liver Fluke - Clonorchis sinensis -

Tuberculosis - Mycobacterium tuberculosis -

Bacteria - Bacillus anthracis -

Roundworm (Female) with Labels - Ascaris lumbricoides -

Beef Tapeworm - Taenia saginata -

Beef Tapeworm - Taenia saginata -

Pinworm - Enterobius vermicularis -

Blood Fluke (Male) - Schistosoma mansoni -

Slug Guts with Parasitic Roundworm -

Plasmodium falciparum Smear -

Rabbit (or Dog) Tapeworm - Taenia pisiformis -

Trypanosoma brucei rhodesiense Smear -

Borrelia burgdorferi Spirochetes -

Leishmania donovani Kinetoplastids -
Dog Heartworm - Dirofilaria immitis -

Itch Mite - Sarcoptes scabei -

Dog Tapeworm - Echinococcus granulosus -

Rocky Mountain Spotted Fever (RMSF) - Rickettsia rickettsii -

Pork Worm (Female) - Trichinella spiralis -

Blood Fluke (Male) - Schistosoma mansoni -

Horsehair Worm (Phylum Nematamorpha)